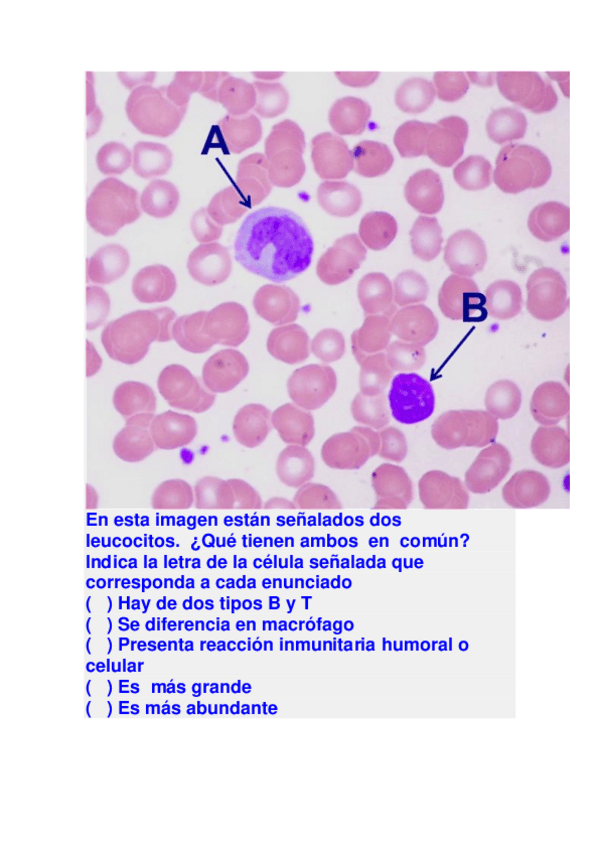

@leyreeegb_
77 Publicaciones
1k Interacciones
4 Seguidores
1 Siguiendo
Lista de publicaciones de leyreeegb_
apuntes
-
TEMARIO FISIOLOGÍA
He publicado nuevos apuntes de 1º Estructura y Función del Cuerpo Humano I: TEMARIO FISIOLOGÍA
apuntes
-
HISTOLOGIA
He publicado nuevos apuntes de 1º Biología: HISTOLOGIA
ejercicios
-
EJERCICIOS REPASO HISTOLOGIA
He publicado nuevos ejercicios de 1º Biología: EJERCICIOS REPASO HISTOLOGIA
apuntes
-
BIOLOGIA CELULAR
He publicado nuevos apuntes de 1º Biología: BIOLOGIA CELULAR
apuntes
-
TEMAS JONATHAN
He publicado nuevos apuntes de 1º Nutrición Humana: TEMAS JONATHAN
apuntes
-
APUNTES CARLOS
He publicado nuevos apuntes de 1º Salud Pública: APUNTES CARLOS
practicas
-
PRÁCTICAS DE AULA
He publicado nuevos practicas de 1º Fundamentos históricos y teóricos de la Enfermería : PRÁCTICAS DE AULA